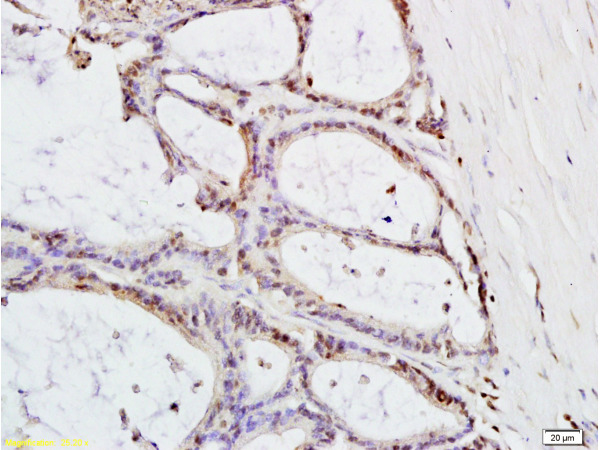

Mouse brain lysates probed with MTLC Polyclonal Antibody, unconjugated (bs-0334R) at 1:300 overnight at 4°C followed by a conjugated secondary antibody at 1:10000 for 60 minutes at 37°C.
MTLC Polyclonal Antibody
BS-0334R
ApplicationsImmunoFluorescence, Western Blot, ELISA, ImmunoCytoChemistry, ImmunoHistoChemistry, ImmunoHistoChemistry Frozen, ImmunoHistoChemistry Paraffin
Product group Antibodies
ReactivityCanine, Human, Mouse, Rat
TargetMYCT1
Overview
- SupplierBioss
- Product NameMTLC Polyclonal Antibody
- Delivery Days Customer16
- ApplicationsImmunoFluorescence, Western Blot, ELISA, ImmunoCytoChemistry, ImmunoHistoChemistry, ImmunoHistoChemistry Frozen, ImmunoHistoChemistry Paraffin
- Applications SupplierWB(1:300-5000), ELISA(1:500-1000), IHC-P(1:200-400), IHC-F(1:100-500), IF(IHC-P)(1:50-200), IF(IHC-F)(1:50-200), IF(ICC)(1:50-200)
- CertificationResearch Use Only
- ClonalityPolyclonal
- Concentration1 ug/ul
- ConjugateUnconjugated
- Gene ID80177
- Target nameMYCT1
- Target descriptionMYC target 1
- Target synonymsMTLC, myc target protein 1, myc target in myeloid cells 1, myc target in myeloid cells protein 1
- HostRabbit
- IsotypeIgG
- Protein IDQ8N699
- Protein NameMyc target protein 1
- ReactivityCanine, Human, Mouse, Rat
- Storage Instruction-20°C
- UNSPSC41116161
References
- Yin Yang Gong Ji pill is an ancient formula with antitumor activity against hepatoma cells. Li Y et al., 2020 Feb 10, J EthnopharmacolRead this paper
- MiR-429 regulates rat liver regeneration and hepatocyte proliferation by targeting JUN/MYC/BCL2/CCND1 signaling pathway. Zhang C et al., 2018 Oct, Cell SignalRead this paper